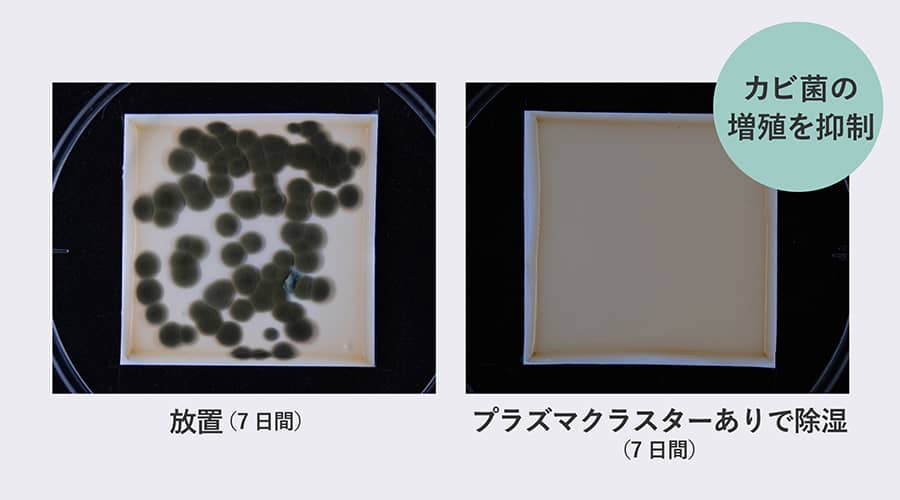
7日間プラズマクラスター無しで放置した場合は付着カビ菌が増殖しますが、7日間プラズマクラスターあり除湿した場合はカビ菌の増殖を抑制を示す実験結果画像。

プラズマクラスター
01プラズマクラスターとは
プラズマクラスターで消臭&カビ抑制
シャープ独自の空気浄化技術、プラズマクラスター7000を搭載し、衣類の消臭や付着カビ菌※4の増殖を抑制します。
プラズマクラスターについて詳しくはこちら
<プラズマクラスター技術の紹介>
プラズマクラスターのメカニズム
カビ菌や菌などの表面から水素原子(H)を素早く奪い取ることで、その作用を抑制。OHラジカルは奪い取った水素原子(H)と結合し、反応後は速やかに水(H₂O)となって空気中に戻ります。
02主な効果
プラズマクラスター除湿機の効果
気になる部屋干し臭の臭いを消臭。さらに付着カビ菌※4も抑制します。

付着カビ菌の抑制効果※4
約90分〜7日後の効果です。約5〜10畳相当の試験空間における実証結果であり、実使用空間での実証結果ではありません。使用場所の状況や使いかたによって効果は異なります。
- ニオイの種類・強さ・対象物の素材などによって、消臭効果は異なります。
- ※a吹き出す風の当たらない部分の消臭や菌の抑制はできません。
03衣類消臭運転
洗いにくい衣類も手軽に消臭※2「衣類消臭運転」
プラズマクラスターの風で、洗いにくいジャケットや制服などに付着したニオイを消臭します。

- ニオイの種類・強さ・対象物の素材などによって、消臭効果は異なります。
- ※吹き出す風の当たらない部分の消臭はできません。